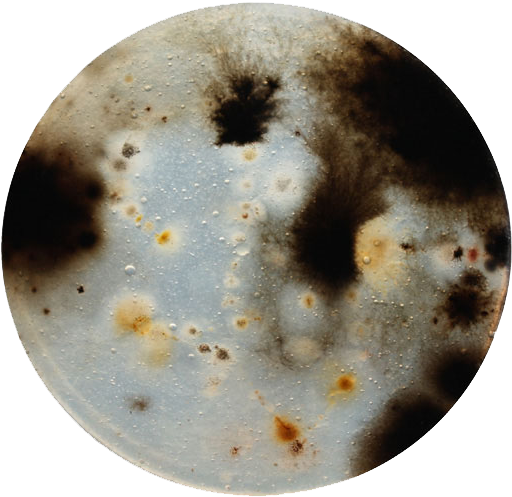
The 24 Best Bacteria Paintings Images On Pinterest - Circle (567x504), Png Download

The 24 Best Bacteria Paintings Images On Pinterest - Circle
Share
: The 24 Best Bacteria Paintings Images On Pinterest - Circle
Format: PNG
Dimensions: 567x504 px
Size: 438 KB
Downloads: 4
Report image
The HD The 24 Best Bacteria Paintings Images On Pinterest - Circle PNG image is a great picture material, whether you are a designer, an advertising marketer, a content writer, or an educator. This PNG image is completely free and you can download it at any time. But not for commercial use. Want to get more high quality PNG images fast? Please use the Search and Advanced Filtering features on PNGkey.com. Here, we also recommend popular search related to The 24 Best Bacteria Paintings Images On Pinterest - Circle, like bacteria png,best friends png,pinterest logo png transparent background.
Short Link (Direct Image Link)
Code for Inserting an Image for Your Blog or Website